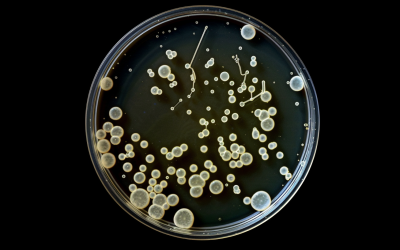

Educational Resources
The following advice and educational materials are intended to help homeowners familiarize themselves with their system. If you are experiencing water supply issues, contact us for a proffesional diagnosis.
(405) 664-6388
Educational Articles From Ace Water Well Services
Why a Home Inspection Usually Does Not Include a Full Water Well Inspection
When buying a home with a private water well, many buyers assume the home inspector will thoroughly evaluate the well system. In Oklahoma, that assumption can create expensive problems. Under Oklahoma Administrative Code Title 158, licensed home inspectors are not...
Oklahoma Water Well Drilling Guide
Thinking about drilling a new water well in Oklahoma? This comprehensive guide is meant to set you on the right track and give you general advice concerning the process, rules and regulations, and costs associated with drilling a new water well. Step One:...
A Deep Dive Into Frost Free Hydrants
There are basically two types of faucets for outdoor use. The ones you typically see on the side of your house that come out from the wall and extend deep into a wall of the house, allowing it to be well insulated and warm past the plunger that is opened and closed...
Quick Guide To Water Well Systems For Home Owners
To help new home owners understand the basics of their residential water well system, we have put together a pamphlet to educate new home owners. If you are a real estate agent and would like to request a set of pamphlets, we can get some sent out to you. Just give us...
Preparing your water well system for freezing winter weather
When that winter season sets upon us, it's a good idea to review your strategy for keeping your water system running smoothly during those nights the temperature drops below freezing. You might be familiar with the commonly promoted strategies that municipalities will...
The Importance of Annual Water Testing: Understanding Total Coliform
If you rely on a private well for your drinking water supply, getting your water tested annually is crucial for detecting potential contamination issues. One of the main things labs test for is the presence of total coliform bacteria. What is Total Coliform? Total...
Resource Links
The following resources are state agencies or public resource organizations related to water wells.